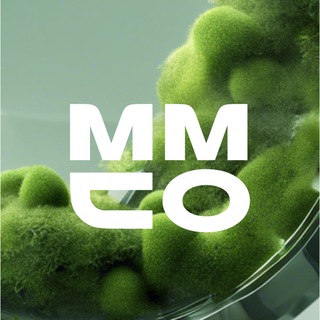

Фонд «Лига выпускников»
Сообщество, где каждый выпускник получит поддержку https://alumni-league.ru/
Channel
- no category
Russia
Followers
1.0K
0
Engagement
-
0
Mean views
-
0
Daily posts
-
0
There is not enough data yet
- 1D
- 1W
- 1M
- All time
There is not enough data yet
- 1D
- 1W
- 1M
- All time
There is not enough data yet
- 1D
- 1W
- 1M
- All time